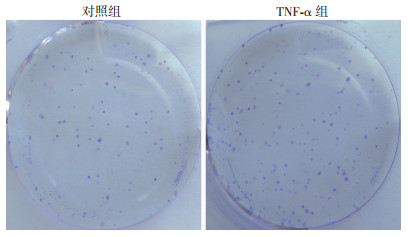

2. 400030 重庆,重庆大学附属肿瘤医院:泌尿肿瘤科
2. Department of Urological Oncology, Chongqing University Cancer Hospital, Chongqing, 400030, China
近年研究表明,肿瘤微环境(tumor microenvironment,TME)中巨噬细胞在促进肿瘤的发生发展过程中扮演着重要的角色,与肿瘤的侵袭、转移等过程密切相关,称为肿瘤相关巨噬细胞(tumor associated machrophage,TAM)[1-2]。巨噬细胞可分成3种表型,即M0、M1和M2。M0为巨噬细胞原始状态,而M1和M2则是巨噬细胞功能形式体现的两个极端[3],M1分泌IL-6、IL-12、TNF-α等大量促炎细胞因子,具有抗感染和抑制肿瘤细胞生长的功能;M2巨噬细胞由IL-4或IL-10等诱导产生,不仅分泌IL-10等细胞因子以抑制相关炎性因子释放,还可分泌TGF-β、EGFR等促进肿瘤细胞的增殖[4-5]。研究表明,在人体多种实体肿瘤组织内浸润的巨噬细胞以M2为主,M2浸润与子宫内膜癌、肺癌等多种实体肿瘤患者的预后呈负相关[6]。有学者利用外部数据发现巨噬细胞浸润可能与膀胱癌患者的不良预后有密切关系[7]。
CLDN10(claudin 10)蛋白是细胞膜骨架蛋白之一,是细胞间紧密连接(tight junction,TJ)的重要构成部分[8-9]。TJ是维持细胞结构以及细胞间连接和细胞间作用的重要通道。而近年研究表明,CLDN10参与人体多种实体瘤的进展过程,并与肾癌、卵巢癌、肠癌患者的预后密切相关[10]。本课题组前期研究结果表明,膀胱癌组织中CLDN10表达升高,TAM可通过调控CLDN10通路促进膀胱癌细胞的上皮-间质转化(epithelial-mesenchymal transformation, EMT)[11]。本研究在此基础上进一步探讨巨噬细胞调控膀胱癌细胞EMT发生的作用机制,以期为治疗膀胱癌提供新的方向和药物靶标。
1 资料与方法 1.1 标本来源收集137例于重庆大学附属肿瘤医院泌尿肿瘤科2000-2015年行根治性膀胱切除术的患者膀胱癌组织石蜡玻片。其中,男性78例,女性59例;根据2010年美国癌症联合委员会(American Joint Committee on Cancer,AJCC)TNM分期,T2期91例,T3期27例,T4期19例。年龄35~81岁,平均62岁。所有癌组织标本经病理诊断为尿路上皮癌。本研究已通过重庆大学附属肿瘤医院伦理委员会批准(CZLS2022254-A)。
1.2 细胞株鼠源巨噬细胞株RAW264.7和鼠源膀胱癌细胞株MB49由中山大学肿瘤防治中心实验室馈赠。均在含10%小牛血清、100 U/mL青-链霉素的1640的培养基中培养,培养器皿置于37 ℃,5%CO2的湿化培养箱中。
1.3 免疫组化实验按照既往报道中描述步骤[11],将石蜡玻片依次进行脱蜡,抗原修复,CLDN10一抗,二抗,染色等步骤后在显微镜下观察抗体染色情况,并对染色强度和范围进行评分,以评估CLDN10的表达情况。染色强度评分:无染色为0分,轻度染色为1分,中度染色为2分,强染色为3分;染色范围评分:染色范围0%为0分,≤30%为1分,>30%~60%为2分,>60%为3分。总体评分=强度评分×范围评分,计算出cut-off值=4分,将评分 < 4分定义为低表达,≥4分定义为高表达。
1.4 Western blot实验将RAW264.7细胞与MB49细胞共同培养72 h后,弃去游离的RAW264.7细胞,用细胞裂解液在冰上裂解MB49细胞,离心、分离蛋白上清液。配制SDS电泳凝胶,依次通过转膜、抗体孵育等步骤,用CLDN10、Snail、Twist、GAPDH、E-cadherin等一抗检测相应蛋白的表达。
1.5 免疫荧光实验取对数生长期的细胞接种于6孔板,待培养结束后用4%多聚甲醛固定,0.5%Triton X-100室温下通透20 min,滴加山羊血清封闭30 min,加入免疫荧光标记的一抗在4 ℃孵育过夜,弃去一抗并清洗3遍后加入荧光二抗,室温下孵育1 h。滴加DAPI避光孵育5 min,清洗3遍后滴加含抗荧光淬灭剂的封闭液,在荧光显微镜下采集图像。
1.6 细胞克隆实验接种500个对数生长期的MB49细胞,常规培养条件下培养1~2周。实验组为同期加入RAW264.7细胞与MB49细胞共培养,对照组则不加入RAW264.7细胞。待培养皿中出现肉眼可见的克隆时,终止培养。弃去上清液,经冲洗、固定、染色后在显微镜(低倍镜)计数>10个细胞的克隆数。最后计算克隆形成率。
1.7 siRNA实验采用Lipofectamine 2000试剂,按照试剂说明书,将si-TNF-α质粒转染RAW264.7细胞,瞬时敲低TNF-α在细胞中的表达。
1.8 统计学分析使用R语言3.6.3和Python 3.7软件进行统计学分析。分类变量使用χ2检验,连续性变量根据正态分布情况采用t检验或者Mann-Whitney U检验,KM生存曲线采用Log Rank秩和检验,生存分析采用Cox比例风险模型。P < 0.05表示差异具有统计学意义。
2 结果 2.1 CLDN10在膀胱癌组织中的表达情况用免疫组化(immunohistochemical, IHC)实验检测CLDN10在膀胱癌组织中的表达情况,并对CLDN10的表达强弱进行评分。结果发现,CLDN10在68例组织中高表达,在69例组织中低表达(图 1)。

|
| A:CLDN10高表达;B:CLDN10低表达 图 1 IHC检测CLDN10在膀胱癌组织中的表达 |
2.2 CLDN10的表达与患者临床资料的相关性分析
将CLDN10的表达情况与患者的年龄、分期等临床资料进行相关性分析,发现其与肿瘤(tumor, T)分期、淋巴结转移和总体生存(overall survival,OS)、肿瘤无复发生存(recurrence-free survival,RFS)密切相关,与年龄、性别则不相关(表 1)。
| 指标 | n | CLDN10高表达 (n=68) |
CLDN10低表达 (n=69) |
P值 |
| 年龄/岁 | ||||
| < 60 | 57 | 27 | 30 | 0.654 |
| ≥60 | 80 | 41 | 39 | |
| 性别 | ||||
| 男性 | 78 | 35 | 43 | 0.772 |
| 女性 | 59 | 33 | 26 | |
| T分期 | ||||
| T2 | 91 | 52 | 39 | 0.014 |
| T3 | 27 | 12 | 15 | |
| T4 | 19 | 4 | 15 | |
| 淋巴结转移 | ||||
| 否 | 98 | 56 | 42 | 0.005 |
| 是 | 39 | 12 | 27 | |
| OS | ||||
| 是 | 53 | 22 | 31 | 0.048 |
| 否 | 84 | 46 | 38 | |
| RFS | ||||
| 是 | 61 | 38 | 23 | 0.008 |
| 否 | 76 | 30 | 46 |
2.3 CLDN10不同表达水平患者OS分析
结果显示,CLDN10低表达患者中位OS显著高于CLDN10高表达患者(104.5 vs 51.6个月,P=0.002 9, 图 2)。

|
| 图 2 CLDN10高低表达膀胱癌患者的总体生存率分析 |
2.4 CLDN10不同表达水平患者RFS分析
结果显示,CLDN10低表达患者中位RFS为80.1个月,CLDN10高表达患者中位RFS为18.3个月,CLDN10高表达患者的中位RFS显著低于低表达患者(P=0.001 5,图 3)。

|
| 图 3 CLDN10高低表达膀胱癌患者的RFS分析 |
2.5 TNF-α可提高膀胱癌细胞株MB49的细胞克隆形成能力
鼠源膀胱癌细胞株MB49加入外源性TNF-α后,发现MB49细胞的克隆数目增多(图 4)。
|
| 图 4 平板克隆实验检测TNF-α对MB49细胞增殖能力的影响 |
2.6 TNF-α促进MB49细胞EMT发生
MB49细胞培养基内加入外源性TNF-α共培养后,Western blot检测细胞内EMT相关指标的表达发现,与对照组比较,Snail、Vimentin、Twist的蛋白表达水平升高,E-cadherin的蛋白表达水平下降(P < 0.05, 图 5)。

|
|
A:Western blot检测结果;B:蛋白半定量分析结果 a: P < 0.05,与对照组比较 图 5 Western blot检测TNF-α对MB49细胞EMT的影响 |
2.7 TNF-α促进CLDN10在MB49细胞内的表达增加
免疫荧光实验检测发现,TNF-α作用MB49细胞后,CLDN10在细胞内的聚集增加(图 6)。

|
| 图 6 免疫荧光实验检测TNF-α对MB49细胞内CLDN10表达的影响 |
2.8 RAW264.7细胞促进MB49细胞EMT
将RAW264.7细胞与MB49细胞共培养后,检测MB49细胞内EMT相关蛋白的表达变化。结果发现,与对照组比较,共培养后MB49细胞内的Snail、Vimentin、Twist的蛋白表达水平升高,而E-cadherin蛋白的表达水平下降(P < 0.05, 图 7)。

|
|
A:Western blot检测结果;B:蛋白半定量分析结果 a: P < 0.05,与对照组比较 图 7 Western blot检测RAW264.7细胞对MB49细胞EMT的影响 |
2.9 RAW264.7细胞分泌TNF-α以促进MB49细胞内EMT
用siRNA干扰技术敲低RAW264.7细胞内TNF-α的表达后,将RAW264.7细胞与MB49细胞共培养,用Western blot检测敲低RAW264.7细胞内TNF-α对MB49细胞EMT相关指标蛋白表达的影响。结果表明,与对照组比较,MB49细胞内Snail、Vimentin、Twist的蛋白表达水平降低(P < 0.05, 图 8)。

|
|
A:Western blot检测结果;B:蛋白半定量分析结果 a: P < 0.05,与对照组比较 图 8 Western blot检测敲低RAW264.7细胞TNF-α对MB49细胞EMT的影响 |
3 讨论
以肿瘤微环境内免疫细胞为靶点的免疫治疗是目前肿瘤药物治疗的热点之一,例如以PD-1/PD-L1单抗作为代表的免疫检查点抑制剂治疗在临床上取得了显著的疗效[12-14]。PD-1/PD-L1药物在临床取得的显著疗效无疑开启了抗肿瘤药物治疗的新篇章。但是,免疫治疗方案仍然面临反应率低、作用效果不确切等诸多问题。同为肿瘤微环境中免疫浸润细胞的重要组成部分,巨噬细胞在肿瘤进展、耐药等方面的作用正被大众逐步认识,但其在促进肿瘤发生发展中的作用及分子机制尚不明确。
膀胱癌是我国人群泌尿系统发病率较高、预后较差的恶性肿瘤之一。本课题组前期研究结果发现,膀胱癌中M2型巨噬细胞的浸润增多,进一步通过基因测序的方法筛选出与TAM作用相关的CLDN10基因,TAM可能通过CLDN10介导EMT机制促进膀胱癌的增殖和转移[11]。
3.1 巨噬细胞分泌TNF-α促进肿瘤细胞的增殖巨噬细胞对肿瘤细胞的多重作用与细胞间分子信号传递作用密切相关。巨噬细胞通过分泌TNF-α作用于肿瘤细胞后引起肿瘤细胞内一连串信号反应,导致肝癌、皮肤癌细胞的增殖[15-16]。本研究采用外源性TNF-α作用于膀胱癌细胞后可促进肿瘤细胞的增殖;将敲低TNF-α的巨噬细胞与膀胱癌细胞共培养,发现膀胱癌细胞的克隆形成能力减弱,提示TNF-α在巨噬细胞介导的促增殖机制中起重要作用。
作为细胞间紧密连接的重要构成,CLDN10的表达多寡与细胞间的运动密切相关。理论上,细胞膜CLDN10表达增多,细胞间连接紧密性增加,细胞间运动减少,肿瘤细胞发生转移的能力减弱。但事实上,CLDN10在不同肿瘤中的表达和作用体现并不一致。YANG等[17]报道CLDN10表达增加可以抑制肾透明细胞癌细胞的生长和转移;而RAO等[18]报道低表达CLDN10的胃癌患者预后更佳。本研究发现高表达CLDN10的患者预后较差,低表达CLDN10的患者预后相对较好;CLDN10表达高低与患者的T、N分期密切相关。单因素和多因素分析结果皆表明,CLDN10是膀胱癌患者预后的有效预测因子,可作为膀胱癌患者预后的生物标志物。
3.2 巨噬细胞分泌TNF-α促进肿瘤细胞EMTEMT是癌细胞发生转移的主要标志。本研究结果表明,TNF-α可促进膀胱癌细胞内EMT主要相关蛋白Snail、Vimentin和Twist的表达,敲低巨噬细胞TNF-α后膀胱癌细胞内EMT相关蛋白的表达水平下降,说明巨噬细胞可通过TNF-α通路调控膀胱癌细胞EMT的发生。有研究表明,TNF-α不仅促进claudin蛋白的表达,还会导致claudin从细胞膜脱落至胞浆内与β-catenin结合,并促进β-catenin进入细胞核内从而启动β-catenin信号通路介导的肿瘤细胞增殖和EMT[19-20]。β-catenin是一种重要的转录因子,β-catenin参与的Wnt/β-catenin信号通路是调控肿瘤细胞EMT的重要通路之一。巨噬细胞可通过向肿瘤细胞分泌Wnt以启动细胞内Wnt/β-catenin信号通路,导致肿瘤细胞EMT的发生[21]。本研究证实,TNF-α可促进CLDN10在MB49细胞内的表达,从而参与CLDN10介导的Wnt/β-catenin信号通路的调控,引起膀胱细胞的增殖和转移。
综上所述,本研究应用鼠源巨噬细胞模型揭示了巨噬细胞通过TNF-α/CLDN10/β-catenin通路调控膀胱癌细胞EMT发生的分子机制,但是仍有许多机制有待进一步探索。巨噬细胞作为肿瘤免疫微环境中重要的组成部分,其对肿瘤的多重作用机制将成为肿瘤免疫治疗的重要靶点。
| [1] |
SHOJAEE P, MORNATA F, DEUTSCH A, et al. The impact of tumor associated macrophages on tumor biology under the lens of mathematical modelling: a review[J]. Front Immunol, 2022, 13: 1050067. |
| [2] |
ZHENG X L, JIANG K, XIAO W J, et al. CD8+ T cell/cancer-associated fibroblast ratio stratifies prognostic and predictive responses to immunotherapy across multiple cancer types[J]. Front Immunol, 2022, 13: 974265. |
| [3] |
ARAS S, ZAIDI M R. TAMeless traitors: macrophages in cancer progression and metastasis[J]. Br J Cancer, 2017, 117(11): 1583-1591. |
| [4] |
ZHANG H Y, LI R C, CAO Y F, et al. Poor clinical outcomes and immunoevasive contexture in intratumoral IL-10-producing macrophages enriched gastric cancer patients[J]. Ann Surg, 2022, 275(4): e626-e635. |
| [5] |
WANG H G, YUNG M M H, NGAN H Y S, et al. The impact of the tumor microenvironment on macrophage polarization in cancer metastatic progression[J]. Int J Mol Sci, 2021, 22(12): 6560. |
| [6] |
LOPEZ-YRIGOYEN M, CASSETTA L, POLLARD J W. Macrophage targeting in cancer[J]. Ann N Y Acad Sci, 2021, 1499(1): 18-41. |
| [7] |
JIN S M, ZENG H, LIU Z P, et al. Stromal tumor-associated macrophage infiltration predicts poor clinical outcomes in muscle-invasive bladder cancer patients[J]. Ann Surg Oncol, 2022, 29(4): 2495-2503. |
| [8] |
HIROHASHI S, KANAI Y E. Cell adhesion system and human cancer morphogenesis[J]. Cancer Sci, 2003, 94(7): 575-581. |
| [9] |
TSUKITA S, FURUSE M, ITOH M. Multifunctional strands in tight junctions[J]. Nat Rev Mol Cell Biol, 2001, 2(4): 285-293. |
| [10] |
HASHIMOTO I, OSHIMA T. Claudins andgastric cancer: an overview[J]. Cancers, 2022, 14(2): 290. |
| [11] |
袁刚军, 韩娜, 谭星亮, 等. 肿瘤微环境中M2巨噬细胞调控CLDN10通路促进膀胱癌细胞的上皮-间质转化[J]. 第三军医大学学报, 2021, 43(23): 2525-2531. YUAN G J, HAN N, TAN X L, et al. M2 macrophages promotes bladder cancer EMT through CLDN10 involved signaling pathway in tumor micro-environment[J]. J Third Mil Med Univ, 2021, 43(23): 2525-2531. |
| [12] |
PATSOUKIS N, WANG Q, STRAUSS L, et al. Revisiting the PD-1 pathway[J]. Sci Adv, 2020, 6(38): eabd2712. |
| [13] |
TAYLOR G, KUMAR S, BRENCHLEY P, et al. Immunosurveillance in pre-malignant occupational bladder disease[J]. Int J Cancer, 1979, 23(4): 487-493. |
| [14] |
CATALONA W J. Commentary on the immunobiology of bladder cancer[J]. J Urol, 1977, 118(1): 2-6. |
| [15] |
CHEN Y X, WEN H H, ZHOU C, et al. TNF-α derived from M2 tumor-associated macrophages promotes epithelial-mesenchymal transition and cancer stemness through the Wnt/β-catenin pathway in SMMC-7721 hepatocellular carcinoma cells[J]. Exp Cell Res, 2019, 378(1): 41-50. |
| [16] |
MOORE R J, OWENS D M, STAMP G, et al. Mice deficient in tumor necrosis factor-alpha are resistant to skin carcinogenesis[J]. Nat Med, 1999, 5(7): 828-831. |
| [17] |
YANG W P, ZHANG K N, ZHANG Z D, et al. Claudin-10 overexpression suppresses human clear cell renal cell carcinoma growth and metastasis by regulating ATP5O and causing mitochondrial dysfunction[J]. Int J Biol Sci, 2022, 18(6): 2329-2344. |
| [18] |
RAO X H, JIANG J L, LIANG Z H, et al. Down-regulated CLDN10 predicts favorable prognosis and correlates with immune infiltration in gastric cancer[J]. Front Genet, 2021, 12: 747581. |
| [19] |
BHAT AA, AHMAD R, UPPADA S B, et al. Claudin-1 promotes TNF-α-induced epithelial-mesenchymal transition and migration in colorectal adenocarcinoma cells[J]. Exp Cell Res, 2016, 349(1): 119-127. |
| [20] |
BHAT AA, UPPADA S, ACHKAR I W, et al. Tight junction proteins and signaling pathways in cancer and inflammation: a functional crosstalk[J]. Front Physiol, 2019, 9: 1942. |
| [21] |
COSIN-ROGER J, ORTIZ-MASIÀ M D, BARRACHINA M D. Macrophages as an emerging source of Wnt ligands: relevance in mucosal integrity[J]. Front Immunol, 2019, 10: 2297. |




